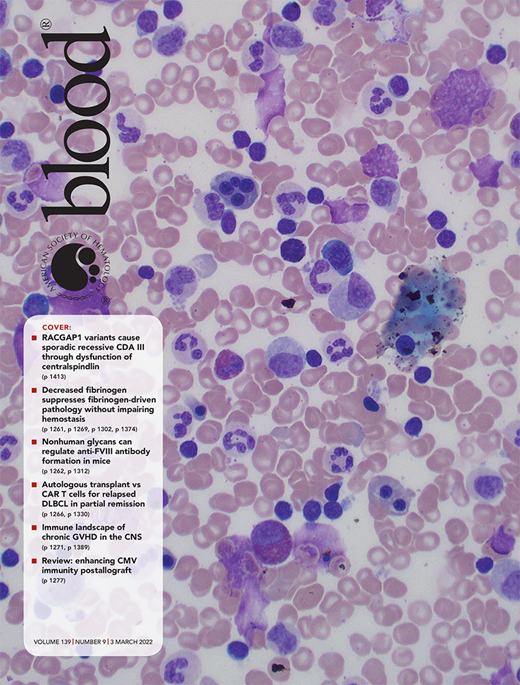
Blood Cover Image for Volume 139, Issue 9

In The Art of War, thought to be written more than 2500 years ago, the Chinese general Sun Tzu gives military advice on how best to defeat the opposition. Key points of his advice include “Know your enemy,” “Exploit your enemy’s weaknesses, avoid his strengths,” and “The supreme art of war is to subdue the enemy without fighting.” Much of Sun Tzu’s sixth century wisdom can translate into helpful advice for some of our modern tasks; for example, business transactions and negotiations or, closer to our own daily activities, battles against disease.
In this issue of Blood, Juang et al1 describe how “subduing” fibrinogen by delivering silencing small interfering RNA (siRNA) can be beneficial in various disease models.
Why would one want to silence fibrinogen? Indeed, with fibrin, produced by thrombin-mediated cleavage, fibrinogen plays important roles in many physiological processes that are essential for human health.2,3 The formation of a stable blood clot, which contains polymerized and cross-linked fibrin, is crucial to prevent blood loss and initiate wound healing. The complete absence of fibrinogen due to mutation of the fibrinogen-encoding genes causes congenital afibrinogenemia, a life-threatening bleeding disorder that can also lead to thrombotic complications.4 Even reduced fibrinogen levels <1.5 g/L (normal levels range between 2 and 4 g/L) can lead to severe bleeding or thrombosis under certain challenging circumstances, such as pregnancy or surgery.
On the other hand, other diseases are the consequence of elevated levels of fibrinogen. Inflammation leads to elevated fibrinogen and hypercoagulability, a risk factor for cardiovascular disease.2 The source and localization of fibrin(ogen) also has clinical implications. Through its immunomodulatory effects, fibrin(ogen) has been associated with metabolic diseases such as obesity and diabetes but also cancer development and progression. Although fibrin(ogen) is important for host defense against pathogens, in other settings it enhances bacterial virulence.
For these reasons, several efforts have aimed to reduce circulating fibrinogen, either nonspecifically by reducing inflammation or specifically by using fibrinogen-cleaving snake venoms such as ancrod5 or small molecule screens to identify molecules that target fibrinogen synthesis or secretion.6
In the study directed by Christian Kastrup from the Blood Research Institute at the University of British Columbia, the authors investigated the safety and efficacy of modulating plasma fibrinogen levels by delivery of a single dose of lipid nanoparticle-encapsulated siRNA targeting the fibrinogen α-chain mRNA (siFga) in mouse models of disease.1 Circulating fibrinogen levels were reduced to between 32% of normal and 5% of normal depending on the dose administered, allowing researchers to study the effects of a range of fibrinogen levels for 2 to 3 weeks. Whereas clots formed ex vivo using blood from siFga-treated mice with an intermediate dose were more fragile, hemostasis was not severely compromised in 2 bleeding models (ie, saphenous vein punctures and tail transections) because the bleeding time and amount of blood loss were unchanged by the treatment. Thus, these approaches can be considered globally safe regarding general hemostatic functions if residual fibrinogen is maintained above a certain threshold, estimated to be ∼1 g/L in humans.
The authors should be complimented for submitting a complete body of work and studying the effect of reducing fibrinogen in not 1 but 3 mouse models of fibrin(ogen)-driven pathologies: an endotoxemia model induced by intraperitoneal injection of lipopolysaccharide, a peritonitis model obtained by intraperitoneal injection of thioglycolate, and an experimental metastasis model analyzing the number of lung metastases formed from lung carcinoma cells injected into the tail vein. In all 3 models, reducing fibrin(ogen) was beneficial for the outcome (see figure). Treatment with siFga suppressed the acute phase response, reduced d-dimers and proinflammatory cytokine levels in the endotoxemia model, restored normal macrophage migration in plasminogen-deficient mice in the peritonitis model, and significantly reduced the metastatic potential of lung carcinoma cells.
Treatment with siFga improves the outcome in mouse models of fibrin(ogen)-driven pathologies.
Treatment with siFga improves the outcome in mouse models of fibrin(ogen)-driven pathologies.
What about silencing human fibrinogen with siRNAs? The feasibility of this approach was also tested by the authors in vitro using the human hepatoma cell line HuH7. FGA mRNA was significantly reduced in cells transfected with human siFga, demonstrating the potential for its use in clinical applications.1 Encouragingly, the first siRNA-based treatment of a human disease has been approved for use in the clinic for patients with transthyretin-mediated amyloidosis.7 We should expect to see many more similar therapeutic protocols in the future. Certainly, Juang and coauthors have shown that silencing the multiple effects of fibrin(ogen) is likely to be beneficial for many fibrin(ogen)-dependent pathologies, including cancer.
Conflict-of-interest disclosure: The author declares no competing financial interests.